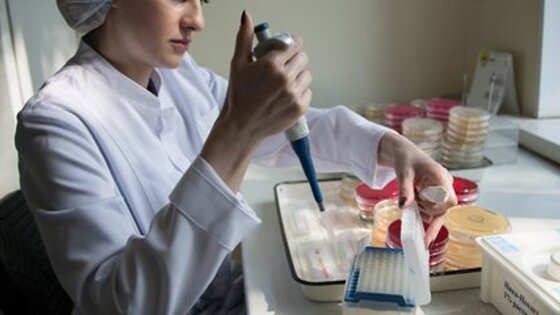

В рамках второго этапа "Я выбираю здоровое будущее!" за два с половиной месяца бесплатный онкоскрининг в Москве прошли 118 тысяч человек. Об этом рассказал глава департамента здравоохранения Алексей Хрипун..
"Мы проводим такие мероприятия регулярно, постоянно расширяя и предлагая жителям новые возможности и форматы. Программа по ранней диагностике наиболее распространенных онкозаболеваний “Я выбираю здоровое будущее!” получила большое количество позитивных отзывов, и подобные акции мы будем проводить и в дальнейшем", – сказал он.
Как отмечает портал мэра и правительства Москвы, с момента старта программы обследование прошли 95 тысяч женщин и 23 тысячи мужчин. Во время обследования у женщин выявлялась предрасположенность к раку молочной железы и яичников. У мужчин определяли наличие признаков рака предстательной железы.
Участники проекта "Активный гражданин" высоко оценили городскую программу по раннему выявлению онкологических заболеваний "Я выбираю здоровое будущее!". Голосование провели в разделе "Городские новинки".
По данным опроса, более 87% респондентов, то есть примерно 110 тысяч человек, оценили программу на отлично. В голосовании приняли участие в общей сложности более 126 тысяч москвичей. Программа "Я выбираю здоровое будущее!" проходила в столице с 7 июля до 22 сентября.
Ранее сообщалось, что более 10 тысяч жительниц Москвы прошли бесплатную диагностику рака груди в рамках специальной акции, приуроченной к Международному дню борьбы против рака молочной железы.
За две недели онкоскрининг прошли более 10 тысяч москвичек. Пациенткам до 35 лет делали УЗИ, женщинам старшего возраста – маммографию. В итоге 100 женщин с подозрением на рак груди направлены в онкологические диспансеры по месту жительства для дополнительного обследования и лечения. Еще у тысячи пациенток были найдены узловые доброкачественные образования, а у более чем четырех тысяч обследованных москвичек врачи выявили фиброзы.